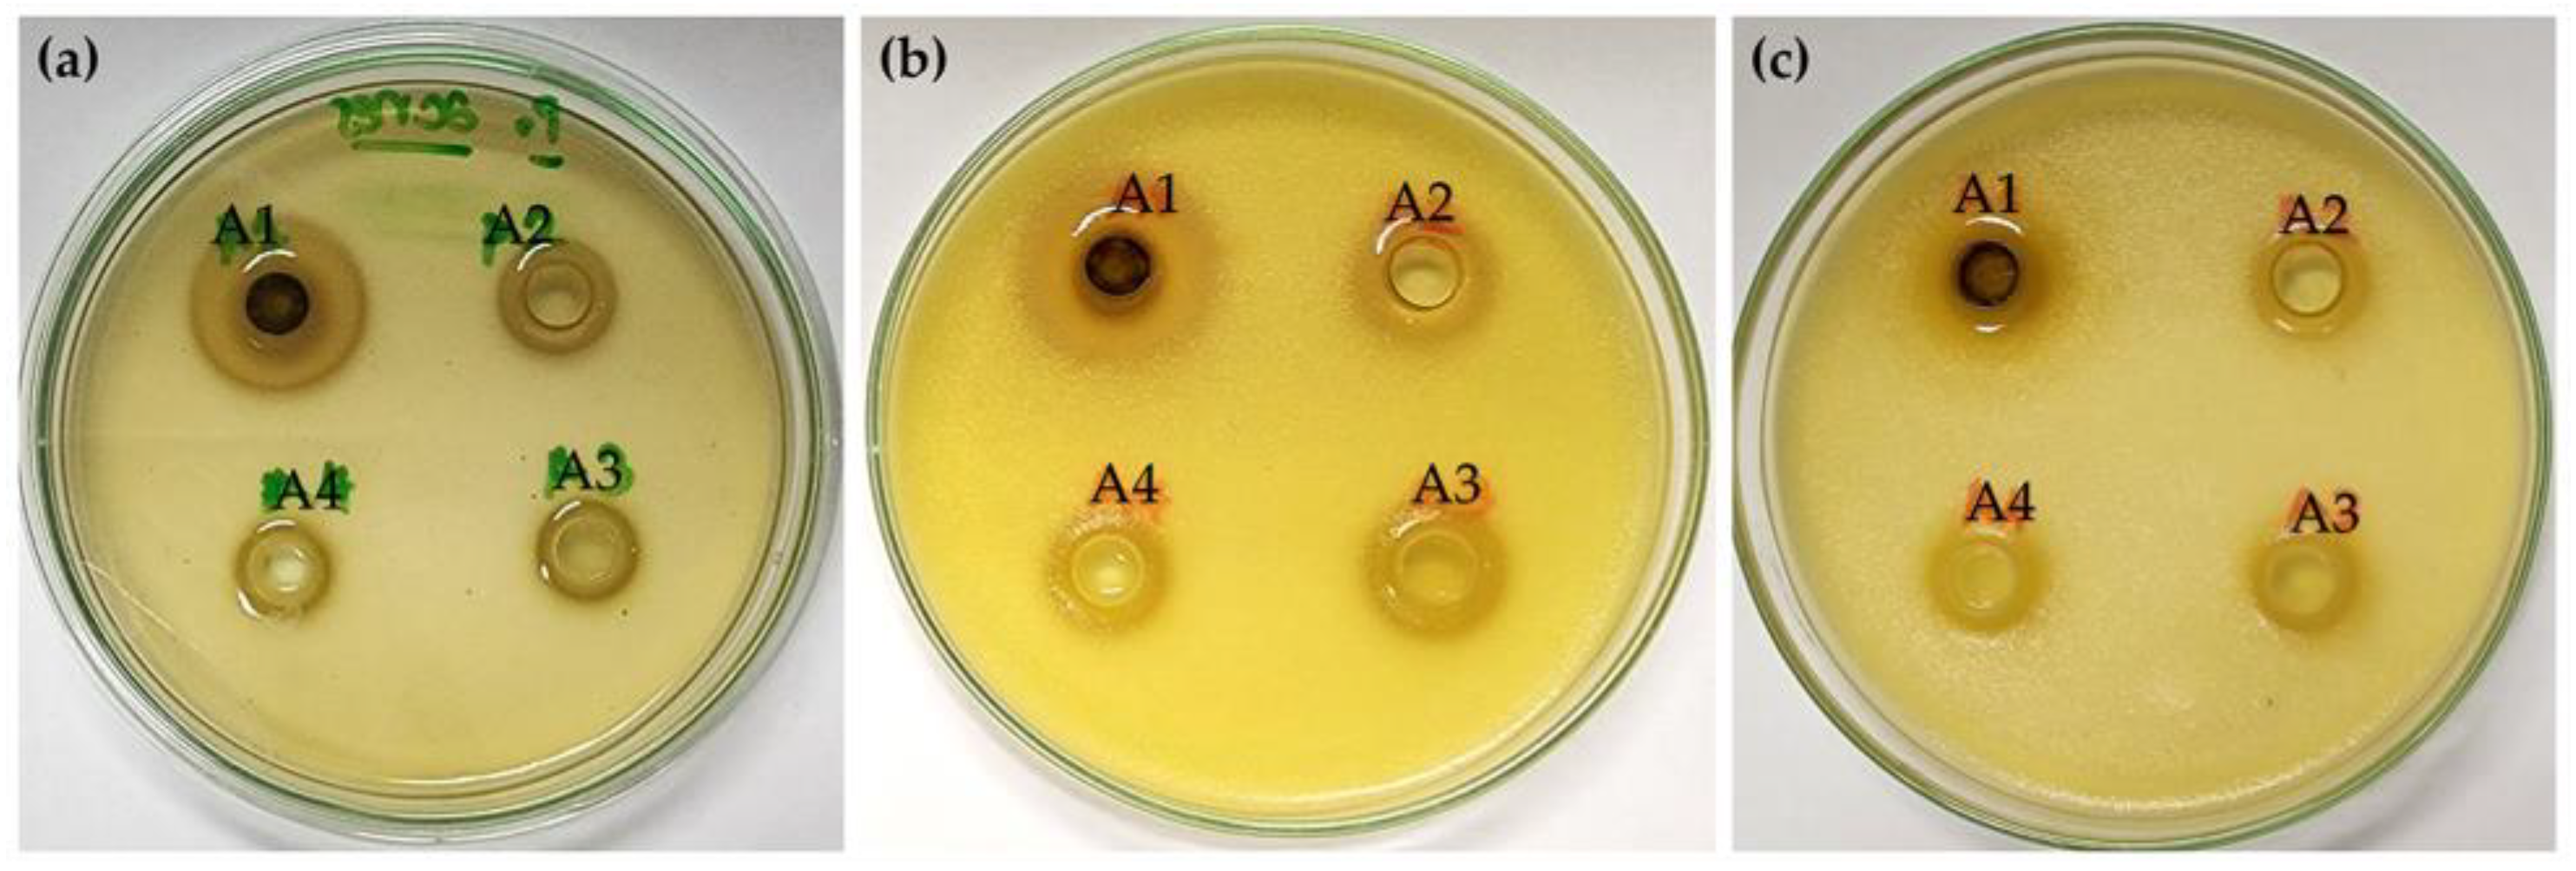
Antibiotics 13 00108 g003

Antimicrobial Properties Related to Anti-Acne and Deodorant Efficacy of Hedychium coronarium J. Koenig Extracts from Pulsed Electric Field Extraction
Abstract
1. Introduction
2. Results and Discussion
2.1. H. coronarium Extracts
2.2. Chemical Compositions of H. coronarium Extracts
2.3. Anti-Acne Activities of H. coronarium Extracts
2.4. Antimicrobial Activities Related to Deodorant Effects of H. coronarium Extracts
2.5. Irritation Properties of H. coronarium Extracts
3. Materials and Methods
3.1. Plant Materials
3.2. Bacterial Strains
3.3. Chemical Materials
3.4. Extraction Methodologies
3.4.1. Conventional Solvent Extraction
3.4.2. PEF Extraction
3.5. Chemical Composition Determination by High Performance Liquid Chromatography (HPLC)
3.6. Biological Activities Determination
3.6.1. Bacteria Strain for Determination of Anti-Acne Activities
3.6.2. Bacteria Strains for Determination of Antimicrobial Activities Related to Deodorant Effects
3.6.3. Agar-Well Diffusion Method
3.6.4. Broth Dilution Method
3.7. Hen’s Egg-Chorioallantoic Membrane Test (HET-CAM Test)
3.8. Statistical Analysis
4. Conclusions
Author Contributions
Funding
Institutional Review Board Statement
Informed Consent Statement
Data Availability Statement
Acknowledgments
Conflicts of Interest
References
- Chan, E.W.C.; Wong, S.K. Phytochemistry and pharmacology of ornamental gingers, Hedychium coronarium and Alpinia purpurata: A review. J. Integr. Med. 2015, 13, 368–379. [Google Scholar] [CrossRef] [PubMed]
- Matsuda, H.; Morikawa, T.; Sakamoto, Y.; Toguchida, I.; Yoshikawa, M. Labdane-type diterpenes with inhibitory effects on increase in vascular permeability and nitric oxide production from Hedychium coronarium. Bioorg. Med. Chem. 2002, 10, 2527–2534. [Google Scholar] [CrossRef] [PubMed]
- Das, R.; Nayak, R.K. Ethnomedicinal uses, phytochemical analysis and antibacterial activity of Hedychium coronarium J. Koenig rhizome. Int. J. Herb. Med. 2023, 11, 1–5. [Google Scholar] [CrossRef]
- Koubaa, M.; Barba, F.J.; Grimi, N.; Mhemdi, H.; Koubaa, W.; Boussetta, N.; Vorobiev, E. Recovery of colorants from red prickly pear peels and pulps enhanced by pulsed electric field and ultrasound. Innov. Food Sci. Emerg. Technol. 2016, 37, 336–344. [Google Scholar] [CrossRef]
- Abbas, F.; Ke, Y.; Zhou, Y.; Yu, Y.; Waseem, M.; Ashraf, U.; Wang, C.; Wang, X.; Li, X.; Yue, Y.; et al. Genome-wide analysis reveals the potential role of MYB transcription factors in floral scent formation in Hedychium coronarium. Front. Plant Sci. 2021, 12, 623742. [Google Scholar] [CrossRef] [PubMed]
- Pachurekar, P.; Dixit, A.K. A review on pharmacognostical phytochemical and ethnomedicinal properties of Hedychium coronarium J. Koenig an endangered medicine. Int. J. Chin. Med. 2017, 1, 49–61. [Google Scholar]
- Ho, J.C. Antimicrobial, mosquito larvicidal and antioxidant properties of the leaf and rhizome of Hedychium coronarium. J. Chin. Chem. Soc. 2011, 58, 563–567. [Google Scholar] [CrossRef]
- Sabulal, B.; George, V.; Dan, M.; Pradeep, N.S. Chemical composition and antimicrobial activities of the essential oils from the rhizomes of four Hedychium species from South India. J. Essent. Oil Res. 2007, 19, 93–97. [Google Scholar] [CrossRef]
- Aziz, M.A.; Habib, M.R.; Karim, M.R. Antibacterial and cytotoxic activities of Hedychium coronarium J. Koenig. J. Agric. Biol. Sci. 2009, 5, 969–972. [Google Scholar]
- Li, Z.L.; Qi, Y.; Mahmut, M.K.; Zou, L.Q. Do you often sniff yourself or others? Development of the Body Odor Sniffing Questionnaire and a cross-cultural survey in China and the USA. Physiol. Behav. 2022, 255, 113934. [Google Scholar] [CrossRef]
- Dréno, B.; Pécastaings, S.; Corvec, S.; Veraldi, S.; Khammari, A.; Roques, C. Cutibacterium acnes (Propionibacterium acnes) and acne vulgaris: A brief look at the latest updates. J. Eur. Acad. Dermatol. Venereol. 2018, 32, 5–14. [Google Scholar] [CrossRef] [PubMed]
- Mayslich, C.; Grange, P.A.; Dupin, N. Cutibacterium acnes as an opportunistic pathogen: An update of its virulence-associated factors. Microorganisms 2021, 9, 303. [Google Scholar] [CrossRef]
- Kanwal, W.; Qamar, A.M.; Nadeem, H.A.; Khan, S.A.; Perveen, R. Awareness of 8th Grade Students Regarding Personal Health and Hygiene. Webology 2021, 18, 4. [Google Scholar]
- Pessemier, B.D.; Daneels, R.; Van De Wiele, T.; Callewaert, C. Underarm Body Odor, the Microbiome, and Probiotic Treatment. In Good Microbes in Medicine, Food Production, Biotechnology, Bioremediation, and Agriculture; Wiley: Hoboken, NJ, USA, 2022; pp. 52–63. [Google Scholar]
- Hara, T.; Matsui, H.; Shimizu, H. Suppression of microbial metabolic pathways inhibits the generation of the human body odor component diacetyl by Staphylococcus spp. PLoS ONE 2014, 9, e111833. [Google Scholar] [CrossRef] [PubMed]
- Ara, K.; Hama, M.; Akiba, S.; Koike, K.; Okisaka, K.; Hagura, T.; Kamiya, T.; Tomita, F. Foot odor due to microbial metabolism and its control. Can. J. Microbiol. 2006, 52, 357–364. [Google Scholar] [CrossRef]
- Al-Talib, H.; Abdulwahab, M.H.; Murad, K.; Amiruddin, N.D.; Mohamed, N.N. Antimicrobial effects of Tetraspanin CD9 peptide against microbiota causing armpit malodour. Antibiotics 2023, 12, 271. [Google Scholar] [CrossRef]
- Melviani, M. Uji Formulasi Spray Scant Diffuse Untuk Memanipulasi Bau Tubuh. J. Farm. Indones. 2022, 19, 80–89. [Google Scholar]
- Indriana, M. Anti-bacterial activity of ethanol extract from the flower of kecombrang (Etlingera elatior Jack.) in vitro. J. Pharm. Sci. 2021, 4, 69–73. [Google Scholar]
- Fish, W.W.; Perkins-Veazie, P.; Collins, J.K. A quantitative assay for lycopene that utilizes reduced volumes of organic solvents. J. Food Compos. Anal. 2002, 15, 309–317. [Google Scholar] [CrossRef]
- Picot-Allain, C.; Mahomoodally, M.F.; Ak, G.; Zengin, G. Conventional versus green extraction techniques—A comparative perspective. Curr. Opin. Food Sci. 2021, 40, 144–156. [Google Scholar] [CrossRef]
- Cvjetko Bubalo, M.; Vidović, S.; Radojčić Redovniković, I.; Jokić, S. Green solvents for green technologies. J. Chem. Technol. Biotechnol. 2015, 90, 1631–1639. [Google Scholar] [CrossRef]
- Sharif, N.; Munir, N.; Hasnain, M.; Naz, S.; Arshad, M. Environmental Impacts of Ethanol Production System. In Sustainable Ethanol and Climate Change: Sustainability Assessment for Ethanol Distilleries, Arshad, M., Ed.; Springer: Cham, Switzerland, 2021; pp. 205–223. [Google Scholar]
- Barba, F.J.; Brianceau, S.; Turk, M.; Boussetta, N.; Vorobiev, E. Effect of alternative physical treatments (ultrasounds, pulsed electric fields, and high-voltage electrical discharges) on selective recovery of bio-compounds from fermented grape pomace. Food Bioproc. Tech. 2015, 8, 1139–1148. [Google Scholar] [CrossRef]
- Yan, L.G.; He, L.; Xi, J. High intensity pulsed electric field as an innovative technique for extraction of bioactive compounds—A review. Crit. Rev. Food Sci. Nutr. 2017, 57, 2877–2888. [Google Scholar] [CrossRef] [PubMed]
- Liu, H.; Hu, D.; Du, P.; Wang, L.; Liang, X.; Li, H.; Lu, Q.; Li, S.; Liu, H.; Chen, X.; et al. Single-cell RNA-seq describes the transcriptome landscape and identifies critical transcription factors in the leaf blade of the allotetraploid peanut (Arachis hypogaea L.). Plant Biotechnol. J. 2021, 19, 2261–2276. [Google Scholar] [CrossRef] [PubMed]
- Mwaurah, P.W.; Kumar, S.; Kumar, N.; Attkan, A.K.; Panghal, A.; Singh, V.K.; Garg, M.K. Novel oil extraction technologies: Process conditions, quality parameters, and optimization. Compr. Rev. Food Sci. Food Saf. 2020, 19, 3–20. [Google Scholar] [CrossRef] [PubMed]
- Barba, F.J.; Putnik, P.; Kovačević, D.B.; Poojary, M.M.; Roohinejad, S.; Lorenzo, J.M.; Koubaa, M. Impact of conventional and non-conventional processing on prickly pear (Opuntia spp.) and their derived products: From preservation of beverages to valorization of by-products. Trends. Food Sci. Tech. 2017, 67, 260–270. [Google Scholar] [CrossRef]
- Fauster, T.; Schlossnikl, D.; Rath, F.; Ostermeier, R.; Teufel, F.; Toepfl, S.; Jaeger, H. Impact of pulsed electric field (PEF) pretreatment on process performance of industrial French fries production. J. Food Eng. 2018, 235, 16–22. [Google Scholar] [CrossRef]
- Toepfl, S. Pulsed Electric Field food treatment-scale up from lab to industrial scale. Procedia Food Sci. 2011, 1, 776–779. [Google Scholar] [CrossRef]
- Arshad, R.N.; Abdul-Malek, Z.; Roobab, U.; Munir, M.A.; Naderipour, A.; Qureshi, M.I.; Bekhit, A.E.; Liu, Z.W.; Aadil, R.M. Pulsed electric field: A potential alternative towards a sustainable food processing. Trends Food Sci. Technol. 2021, 111, 43–54. [Google Scholar] [CrossRef]
- Martínez, J.M.; Delso, C.; Álvarez, I.; Raso, J. Pulsed electric field permeabilization and extraction of phycoerythrin from Porphyridium cruentum. Algal Res. 2019, 37, 51–56. [Google Scholar] [CrossRef]
- Hombach, M.; Bloemberg, G.V.; Böttger, E.C. Effects of clinical breakpoint changes in CLSI guidelines 2010/2011 and EUCAST guidelines 2011 on antibiotic susceptibility test reporting of Gram-negative bacilli. J. Antimicrob. Chemother. 2012, 67, 622–632. [Google Scholar] [CrossRef]
- Song, M.; Seo, S.H.; Ko, H.C.; Oh, C.K.; Kwon, K.S.; Chang, C.L.; Kim, M.B. Antibiotic susceptibility of Propionibacterium acnes isolated from acne vulgaris in Korea. J. Dermatol. 2011, 38, 667–673. [Google Scholar] [CrossRef] [PubMed]
- Biswal, I.; Gaind, R.; Kumar, N.; Mohanty, S.; Manchanda, V.; Khunger, N.; Ramesh, V.; Deb, M. In vitro antimicrobial susceptibility patterns of Propionibacterium acnes isolated from patients with acne vulgaris. J. Infect. Dev. Ctries. 2016, 10, 1140–1145. [Google Scholar] [CrossRef] [PubMed]
- Vattem, D.A.; Shetty, K. Biological functionality of ellagic acid: A review. J. Food Biochem. 2005, 29, 234–266. [Google Scholar] [CrossRef]
- Alfei, S.; Marengo, B.; Zuccari, G. Oxidative stress, antioxidant capabilities, and bioavailability: Ellagic acid or urolithins? Antioxidants 2020, 9, 707. [Google Scholar] [CrossRef] [PubMed]
- Yordi, E.; Molina Pérez, E.; Matos, M.J.; Uriarte, E. Antioxidant and Pro-Oxidant Effects of Polyphenolic Compounds and Structure-Activity Relationship Evidence. In Nutrition, Well-Being and Health; Bouayed, J., Bohn, T., Eds.; InTech: Rijeka, Croatia, 2012; pp. 23–48. [Google Scholar]
- Dryden, M. Reactive oxygen species: A novel antimicrobial. Int. J. Antimicrob. Agents. 2018, 51, 299–303. [Google Scholar] [CrossRef] [PubMed]
- Li, Z.J.; Guo, X.; Dawuti, G.; Aibai, S. Antifungal activity of ellagic acid in vitro and in vivo. Phytother. Res. 2015, 29, 1019–1025. [Google Scholar] [CrossRef]
- Viera, L.M.D.A.L.; Silva, R.S.; da Silva, C.C.; Presgrave, O.A.F.; Boas, M.H.S.V. Comparison of the different protocols of the Hen’s Egg Test-Chorioallantoic Membrane (HET-CAM) by evaluating the eye irritation potential of surfactants. In Vitro Toxicol. 2022, 78, 105255. [Google Scholar] [CrossRef]
- Corrêa, G.D.O.P.; Marcato, D.C.; Ramos, W.S.; Corrêa, M.A.; Cicarelli, R.M.B.; Isaac, V.L.B. In vitro evaluation of the cytotoxicity and eye irritation potential of preservatives widely used in cosmetics. Braz. J. Pharm. Sci. 2022, 58, e20039. [Google Scholar] [CrossRef]
- Tima, S.; Tapingkae, T.; To-Anun, C.; Noireung, P.; Intaparn, P.; Chaiyana, W.; Sirithunyalug, J.; Panyajai, P.; Viriyaadhammaa, N.; Nirachonkul, W.; et al. Antileukaemic cell proliferation and cytotoxic activity of edible golden cordyceps (Cordyceps militaris) extracts. Evid. Based Complement. Altern. Med. 2022, 2022, 5347718. [Google Scholar] [CrossRef]
- Chaiyana, W.; Sirithunyalug, J.; Somwongin, S.; Punyoyai, C.; Laothaweerungsawat, N.; Marsup, P.; Neimkhum, W.; Yawootti, A. Enhancement of the antioxidant, anti-tyrosinase, and anti-hyaluronidase activity of Morus alba L. leaf extract by pulsed electric field extraction. Molecules 2020, 25, 2212. [Google Scholar] [CrossRef]
- Somwongin, S.; Sirilun, S.; Chantawannakul, P.; Anuchapreeda, S.; Yawootti, A.; Chaiyana, W. Ultrasound-assisted green extraction methods: An approach for cosmeceutical compounds isolation from Macadamia integrifolia pericarp. Ultrason. Sonochem. 2023, 92, 106266. [Google Scholar] [CrossRef]
- Rojas, J.; Ndong Ntoutoume, G.M.A.; Martin, P.; Morillo, M. Antibacterial activity and reversal of multidrug resistance of tumor cells by essential oils from fresh leaves, flowers, and stems of Montanoa quadrangularis schultz bipontinus (asteraceae) collected in mérida—Venezuela. Biomolecules 2021, 11, 605. [Google Scholar] [CrossRef]
- Prommaban, A.; Kheawfu, K.; Chittasupho, C.; Sirilun, S.; Hemsuwimon, K.; Chaiyana, W. Phytochemical, antioxidant, antihyaluronidase, antityrosinase, and antimicrobial properties of Nicotiana tabacum L. leaf extracts. Evid. Based Complement. Altern. Med. 2022, 2022, 5761764. [Google Scholar] [CrossRef]
- Pelyuntha, W.; Chaiyasut, C.; Kantachote, D.; Sirilun, S. Cell-free supernatants from cultures of lactic acid bacteria isolated from fermented grape as biocontrol against Salmonella Typhi and Salmonella Typhimurium virulence via autoinducer-2 and biofilm interference. PeerJ 2019, 7, e7555. [Google Scholar] [CrossRef]
- Rahman, M.M.; Richardson, A.; Sofian-Azirun, M. Antibacterial activity of propolis and honey against Staphylococcus aureus and Escherichia coli. Afr. J. Microbiol. Res. 2010, 4, 1872–1878. [Google Scholar]
- Luepke, N.P. Hen’s egg chorioallantoic membrane test for irritation potential. Food Chem. Toxicol. 1985, 23, 287–291. [Google Scholar] [CrossRef]

| Extraction Methods | Yield (% w/w Based on Dried Plant Weight) | |
|---|---|---|
| Rhizome | Leaf | |
| Maceration | 11.0 ± 2.7 a | 10.7 ± 1.0 a,b |
| PEF 10 kV/cm | 1.5 ± 0.6 d | 6.0 ± 0.1 b,c |
| PEF 14 kV/cm | 2.2 ± 0.2 c,d | 6.6 ± 0.4 b |
| PEF 20 kV/cm | 8.9 ± 1.0 a,b | 11.6 ± 3.2 a |
| Extraction Methods | Amount (mg/g Dry Extract Weight) | |||||
|---|---|---|---|---|---|---|
| Kojic Acid | Chlorogenic Acid | EGCG | Rutin | Ellagic Acid | Rosmarinic Acid | |
| Rhizome | ||||||
| Maceration | 0.00 ± 0.00 a | 0.26 ± 0.01 b | 0.04 ± 0.00 b | 0.00 ± 0.00 b | 0.28 ± 0.07 b | 0.03 ± 0.00 b |
| PEF 10 kV/cm | 0.00 ± 0.00 a | 0.00 ± 0.00 d | 0.00 ± 0.00 c | 0.00 ± 0.00 b | 0.00 ± 0.00 c | 0.00 ± 0.00 b |
| PEF 14 kV/cm | 0.00 ± 0.00 a | 0.13 ± 0.00 c | 0.00 ± 0.00 c | 0.00 ± 0.00 b | 0.00 ± 0.00 c | 0.00 ± 0.00 b |
| PEF 20 kV/cm | 0.00 ± 0.00 a | 1.32 ± 0.02 a | 0.16 ± 0.01 a | 0.02 ± 0.00 a | 1.60 ± 0.05 a | 0.13 ± 0.02 a |
| Leaf | ||||||
| Maceration | 16.90 ± 0.10 a | 1.84 ± 0.02 a | 15.28 ± 0.09 a | 4.06 ± 0.07 a | 4.27 ± 0.74 d | 7.22 ± 0.02 a |
| PEF 10 kV/cm | 1.72 ± 0.00 d | 0.04 ± 0.00 d | 1.21 ± 0.00 d | 0.17 ± 0.00 d | 8.24 ± 0.43 c | 0.53 ± 0.02 d |
| PEF 14 kV/cm | 4.28 ± 0.02 c | 0.36 ± 0.00 c | 3.30 ± 0.02 c | 0.93 ± 0.01 c | 15.35 ± 0.46 b | 0.86 ± 0.00 c |
| PEF 20 kV/cm | 10.84 ± 0.07 b | 0.79 ± 0.03 b | 6.97 ± 0.02 b | 1.58 ± 0.03 b | 42.35 ± 1.64 a | 2.85 ± 0.02 b |
| Samples | C. acnes Inhibition Zone (mm) | MIC (µg/mL) | ||
|---|---|---|---|---|
| Rhizome | Leaf | Rhizome | Leaf | |
| Clindamycin 10 µg/mL | 40.2 ± 0.2 a | ≥4.9 | ||
| Penicillin G 50 µg/mL | 16.1 ± 0.4 c | ≥0.8 | ||
| Ampicillin 50 µg/mL | 19.8 ± 0.6 b | ≥0.4 | ||
| 95% v/v Ethanol | 8.5 ± 0.1 e | ND | ||
| H. coronarium extracts | ||||
| Maceration | 9.8 ± 0.0 d | 10.2 ± 0.0 d | ≥1.3 | ≥0.6 |
| PEF 10 kV/cm | 9.1 ± 0.1 e | 9.8 ± 0.0 d | ≥1.3 | ≥5.0 |
| PEF 14 kV/cm | 8.2 ± 0.0 e | 8.4 ± 0.1 d | ≥1.3 | ≥1.3 |
| PEF 20 kV/cm | 9.7 ± 0.1 d | 9.9 ± 0.1 d | ≥1.3 | ≥0.6 |
| Samples | Inhibition Zone (mm) | ||||
|---|---|---|---|---|---|
| S. aureus | B. subtilis | M. luteus | P. aeruginosa | E. coli | |
| Clindamycin 10 µg/mL | 44.3 ± 0.4 a | 40.2 ± 0.4 a | 30.6 ± 0.5 a | 29.2 ± 0.3 a | 28.5 ± 0.3 a |
| Penicillin G 50 µg/mL | 30.0 ± 0.4 c | 16.4 ± 0.2 c | 25.6 ± 0.8 b | 22.5 ± 0.2 b | 22.3 ± 0.2 b |
| Ampicillin 50 µg/mL | 35.5 ± 0.3 b | 19.0 ± 0.2 b | 15.3 ± 0.4 c | 14.1 ± 0.2 c | 14.7 ± 0.1 c |
| 95% v/v Ethanol | 7.8 ± 0.1 e | 8.5 ± 0.1 e | 9.0 ± 0.1 e | 9.5 ± 0.1 | 9.7 ± 0.1 d |
| Rhizome | |||||
| Maceration | 9.5 ± 0.1 d | 11.2 ± 0.0 d | 10.8 ± 0.0 d | 10.8 ± 0.0 d | 9.5 ± 0.0 d |
| PEF 10 kV/cm | 8.2 ± 0.0 e | 8.8 ± 0.1 e | 9.8 ± 0.0 e | 9.8 ± 0.0 e | 9.1 ± 0.0 d |
| PEF 14 kV/cm | 8.1 ± 0.0 e | 9.4 ± 0.1 e | 9.2 ± 0.1 e | 9.2 ± 0.1 e | 8.1 ± 0.1 e |
| PEF 20 kV/cm | 8.3 ± 0.0 e | 9.4 ± 0.0 e | 9.8 ± 0.0 e | 9.8 ± 0.0 e | 9.2 ± 0.1 d |
| Leaf | |||||
| Maceration | 10.1 ± 0.2 d | 12.7 ± 0.0 d | 12.3 ± 0.1 d | 11.8 ± 0.1 d | 9.7 ± 0.1 d |
| PEF 10 kV/cm | 9.5 ± 0.1 d | 9.4 ± 0.0 e | 11.2 ± 0.1 d | 11.2 ± 0.1 d | 9.7 ± 0.0 d |
| PEF 14 kV/cm | 8.2 ± 0.0 e | 10.0 ± 0.1 d | 9.2 ± 0.1 e | 9.2 ± 0.1 e | 8.1 ± 0.1 e |
| PEF 20 kV/cm | 9.2 ± 0.0 d | 10.7 ± 0.1 d | 10.8 ± 0.0 d | 10.8 ± 0.0 d | 9.1 ± 0.1 d |
| Samples | MIC (µg/mL) | ||||
|---|---|---|---|---|---|
| S. aureus | B. subtilis | M. luteus | P. aeruginosa | E. coli | |
| Clindamycin | ≥4.9 | ≥4.9 | ≥4.9 | ≥4.9 | ≥9.8 |
| Penicillin G | ≥0.4 | ≥0.4 | ≥0.8 | ≥0.4 | ≥0.4 |
| Ampicillin | ≥0.4 | ≥0.4 | ≥0.4 | ≥0.4 | ≥0.8 |
| Rhizome | |||||
| Maceration | ≥1.3 | ≥1.3 | ≥1.3 | ≥2.5 | ≥2.5 |
| PEF 10 kV/cm | ≥5.0 | ≥5.0 | ≥2.5 | ≥2.5 | ≥2.5 |
| PEF 14 kV/cm | ≥1.3 | ≥1.3 | ≥1.3 | ≥5.0 | ≥5.0 |
| PEF 20 kV/cm | ≥2.5 | ≥1.3 | ≥1.3 | ≥2.5 | ≥2.5 |
| Leaf | |||||
| Maceration | ≥1.3 | ≥0.6 | ≥0.6 | ≥0.6 | ≥1.3 |
| PEF 10 kV/cm | ≥1.3 | ≥1.3 | ≥1.3 | ≥0.6 | ≥1.3 |
| PEF 14 kV/cm | ≥5.0 | ≥1.3 | ≥1.3 | ≥5.0 | ≥5.0 |
| PEF 20 kV/cm | ≥1.3 | ≥0.6 | ≥0.6 | ≥0.6 | ≥1.3 |
| Substance | Irritation Score (IS) | Irritancy Classification |
|---|---|---|
| Positive control (SLS) | 16.22 ± 0.4 a | Severe irritation |
| Negative control (NSS) | 0.0 ± 0.0 b | No irritation |
| Rhizome | ||
| Maceration | 0.0 ± 0.0 b | No irritation |
| PEF 10 kV/cm | 0.0 ± 0.0 b | No irritation |
| PEF 14 kV/cm | 0.0 ± 0.0 b | No irritation |
| PEF 20 kV/cm | 0.0 ± 0.0 b | No irritation |
| Leaf | ||
| Maceration | 0.0 ± 0.0 b | No irritation |
| PEF 10 kV/cm | 0.0 ± 0.0 b | No irritation |
| PEF 14 kV/cm | 0.0 ± 0.0 b | No irritation |
| PEF 20 kV/cm | 0.0 ± 0.0 b | No irritation |
Disclaimer/Publisher’s Note: The statements, opinions and data contained in all publications are solely those of the individual author(s) and contributor(s) and not of MDPI and/or the editor(s). MDPI and/or the editor(s) disclaim responsibility for any injury to people or property resulting from any ideas, methods, instructions or products referred to in the content. |
© 2024 by the authors. Licensee MDPI, Basel, Switzerland. This article is an open access article distributed under the terms and conditions of the Creative Commons Attribution (CC BY) license (https://creativecommons.org/licenses/by/4.0/).
Share and Cite
Mitchaleaw, M.; Juntrapirom, S.; Bunrod, A.; Kanjanakawinkul, W.; Yawootti, A.; Charoensup, W.; Sirilun, S.; Chaiyana, W. Antimicrobial Properties Related to Anti-Acne and Deodorant Efficacy of Hedychium coronarium J. Koenig Extracts from Pulsed Electric Field Extraction. Antibiotics 2024, 13, 108. https://doi.org/10.3390/antibiotics13010108
Mitchaleaw M, Juntrapirom S, Bunrod A, Kanjanakawinkul W, Yawootti A, Charoensup W, Sirilun S, Chaiyana W. Antimicrobial Properties Related to Anti-Acne and Deodorant Efficacy of Hedychium coronarium J. Koenig Extracts from Pulsed Electric Field Extraction. Antibiotics. 2024; 13(1):108. https://doi.org/10.3390/antibiotics13010108
Chicago/Turabian StyleMitchaleaw, Manasanan, Saranya Juntrapirom, Anurak Bunrod, Watchara Kanjanakawinkul, Artit Yawootti, Wannaree Charoensup, Sasithorn Sirilun, and Wantida Chaiyana. 2024. "Antimicrobial Properties Related to Anti-Acne and Deodorant Efficacy of Hedychium coronarium J. Koenig Extracts from Pulsed Electric Field Extraction" Antibiotics 13, no. 1: 108. https://doi.org/10.3390/antibiotics13010108
APA StyleMitchaleaw, M., Juntrapirom, S., Bunrod, A., Kanjanakawinkul, W., Yawootti, A., Charoensup, W., Sirilun, S., & Chaiyana, W. (2024). Antimicrobial Properties Related to Anti-Acne and Deodorant Efficacy of Hedychium coronarium J. Koenig Extracts from Pulsed Electric Field Extraction. Antibiotics, 13(1), 108. https://doi.org/10.3390/antibiotics13010108







